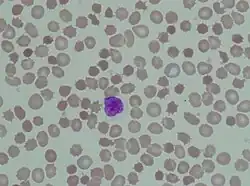

Akanthozyt
Akanthozyten sind eine pathologische Form der Erythrozyten. Sie besitzen infolge eines Missverhältnisses zwischen Zellvolumen und Zellmembran spitze Ausläufer – man nennt sie daher auch „Stachelzellen“. Die Vergrößerung der Zelloberfläche kommt durch eine verstärkte Aufnahme von Cholesterin in die Zellmembran zustande. Akanthozyten kommen unter anderem bei einigen Lebererkrankungen und Bluterkrankungen, nach einer Milzentfernung und bei einigen seltenen neurologischen Erkrankungen, den sogenannten Neuroakanthozytose-Syndromen, vor. Akanthozyten müssen morphologisch abgegrenzt werden von Fragmentozyten und Stechapfelformen.
Methodische Aspekte
Die Stachelform der Erythrozyten kann dem Untersucher bei einem einfachen Blutausstrich entgehen. Wenn die Blutprobe vor der Untersuchung mit NaCl 0,9 % in einer 1:2-Verdünnung versetzt wird, sind die Stachelformen wesentlich deutlicher zu sehen.
Akanthozyten im Urin
Im Rahmen einer Hämaturie können auch im Urin Akanthozyten (Akanthozyturie) auftreten. Der Nachweis erfolgt durch phasenkontrastmikroskopische Untersuchung des Urinsediments. Typisch sind ringförmige Erythrozyten mit bläschenförmigen Ausstülpungen („Micky-Maus-Ohren“). Beträgt der Anteil mehr als 5 % der Erythrozyten im Urinsediment, weist das auf eine Glomerulonephritis oder eine andere Schädigung auf Höhe der Glomeruli als Ursache der Mikrohämaturie hin. Bei allen anderen Ursachen für eine Hämaturie sind keine Akanthozyten zu beobachten.[1]
Einzelnachweise
- ↑ Eveline Wandel et al.: Acanthocyturia—A characteristic marker for glomerular bleeding. In: Kidney International. Nr. 40, 1991, S. 115–120 (nature.com [PDF]).